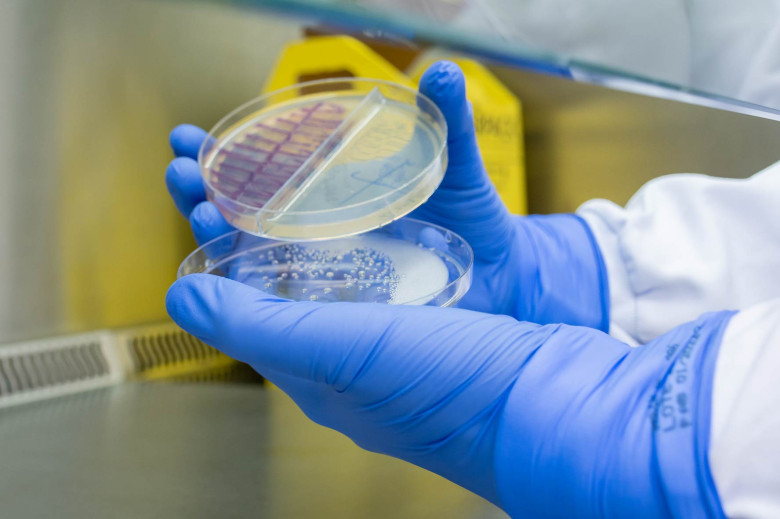
...

Laboratório de Análises Clínicas e Biologia Molecular - Unilab
O Laboratório de Análises Clínicas e Biologia Molecular da Unijuí é um espaço dedicado à realização de exames laboratoriais em materiais biológicos como sangue, urina e fezes, contribuindo para o diagnóstico, acompanhamento e prevenção de diversas enfermidades.
Os atendimentos são realizados por estudantes do curso de Biomedicina, sob supervisão de professores e profissionais habilitados, garantindo qualidade técnica e cuidado ético no atendimento à comunidade.
Além de prestar serviços essenciais, o laboratório integra atividades de ensino, pesquisa e extensão, contribuindo para a formação acadêmica e o compromisso social da instituição.
Serviços ofertados
- Hematologia: análises de plaquetas, leucócitos, hemácias e outros componentes do sangue;
- Bioquímica: exames para controle de colesterol, diabetes, triglicerídeos, creatinina, entre outros marcadores metabólicos;
- Microbiologia: identificação de agentes infecciosos por meio da análise de secreções e outros materiais biológicos;
- Parasitologia: detecção de parasitas intestinais a partir da análise de amostras de fezes;
- Uroanálises: exames da urina para identificação de alterações renais, infecciosas ou metabólicas;
- Imunologia: investigação de doenças imunológicas e infecciosas, como HIV, dengue, hepatites e sarampo;
- Dosagem hormonal: exames para avaliação das funções reprodutivas, tireoidianas e outros sistemas hormonais.
Ijuí
Horário de Atendimento: Segunda a sexta-feira 07h00 às 17h00
Endereço: Rua do Comércio, 3000, Prédio 41,
Sala 41-01, Bairro Universitário, Ijuí - RS
Segunda a sexta-feira 07h00 às 16h30
Endereço: Rua Bento Gonçalves 285,
sala 2, Centro, Ijuí - RS
Contatos: E-mail: unilab@unijui.edu.br